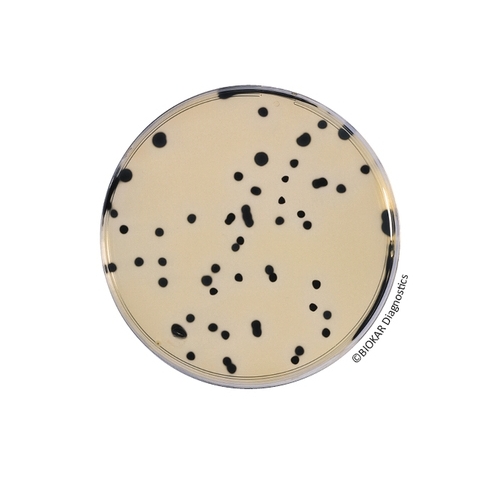
TSC Agar (without D-cycloserine)

TSC (TRYPTONE-SULFITE-CYCLOSERINE) Agar
Tryptone Sulfite Cycloserine Agar was described by Harmon for the selective isolation and enumeration of Clostridium perfringens in water and food samples. The medium was recommended for the enumeration of sulfur-reducing anaerobes from foods of animal origin.
| Ürün Adı | D-cycloserine 200 mg Selective Supplement (qsq 9 lt) |
| Ürün Kodu | BS09208 |
| Miktar | 10 vials of 90 mL (qsp 9 L) |
| Ürün Adı | TSC Agar (without D-cycloserine) |
| Ürün Kodu | BM03908 |
| Miktar | 50 tubes of 20 mL |
| Ürün Adı | TSC Agar (without D-cycloserine) |
| Ürün Kodu | BK031HA |
| Miktar | 500 g |
| Ürün Adı | D-cycloserine 200 mg Selective Supplement |
| Ürün Kodu | BS00608 |
| Miktar | 10 vials qsp 500 mL |
| Ürün Adı | TSC Agar (without D-cycloserine) |
| Ürün Kodu | BM07708 |
| Miktar | 10 vials of 200 mL |